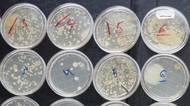

Velký test použitých roušek: Co nosíme denně na obličeji?
Před 5 roky
Redakce Seznam Zpráv dala dohromady 40 použitých roušek a nechala je otestovat v laboratoři. Test ukázal, zda jsou lepší jednorázové, nebo textilní a zda hraje roli, jestli roušku nosíte dvě hodiny, nebo tu stejnou opakovaně.